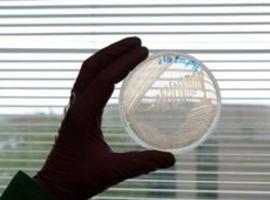

Arriondas.- El Descenso Internacional del Sella dedicará su LXXVI edición, que se celebrará el 4 del próximo mes de agosto, al municipio asturiano de San Martín del Rey Aurelio, según ha acordado el Comité Organizador de la prueba, que también ha decidido el hermanamiento de las aguas del Sella con el Nalón.
Este concejo, de casi 20.000 habitantes, emplazado en la comarca minera del Nalón se une a la relación de comunidades autónomas, ciudades, instituciones y entidades culturales o deportivas a los que la popular prueba piragüística ha distinguido en años anteriores.
La representación de reyes asturianos en la conocida como la "fiesta de las piraguas", instituida por el fundador del Descenso Internacional del Sella, Dionisio de la Huerta, ha convertido a estos en personajes tradicionales de la cita, con protagonismo, entre otros, de el rey Silo que llegaba desde Pravia, Favila desde Cangas o Aurelio desde San Martín.
En la estructura del Sella ideada por Dionisio, los reyes presidían los actos del desfile, la salida y la llegada de una competición lúdico deportiva a la que el rey Aurelio asiste desde hace más de 25 años.
El próximo día 27 de junio se celebrará en Blimea el acto de presentación de la dedicatoria del Descenso Internacional del Sella a San Martín del Rey Aurelio, y esa misma jornada tendrá lugar el hermanamiento de los ríos con el vertido de agua del Sella en el cauce del Nalón.
Además, se inaugurará en la Casa de la Juventud de Sotrondio una exposicíón sobre el Descenso del Sella, en la que se mostrará una recopilación de carteles, fotografías y material de piragüismo.
Eventos como la Expo de Zaragoza, las ciudades de Madrid y Sevilla, entidades como el Grupo Cultura Covadonga, competiciones como el Descenso a Nado de la Ría de Navia y localidades asturianas como Noreña, Cangas de Onís o Infiesto figuran entre las dedicatorias.
A lo largo de sus 75 años de existencia el Sella ha hermanado sus aguas con los principales ríos españoles, Guadalquivir, Ebro y Duero, así como con otros de especial singularidad piragüística como el Duero, Miño, Carrión y Pisuerga.
En 2005 tuvo lugar el primer hermanamiento con un río extranjero al intercambiar aguas con el Brenta, que discurre por el norte de Italia.